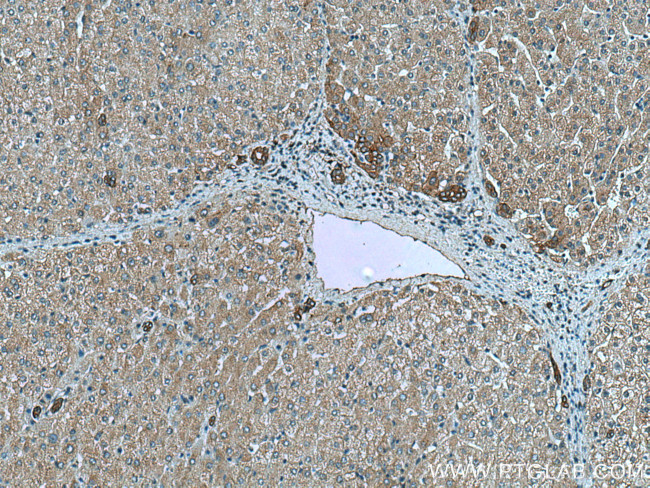
NHE1 Antibody in Immunohistochemistry (Paraffin) (IHC (P))

Search
Proteintech
NHE1 Monoclonal Antibody (3D9F3)
{{$productOrderCtrl.translations['antibody.pdp.commerceCard.promotion.promotions']}}
{{$productOrderCtrl.translations['antibody.pdp.commerceCard.promotion.viewpromo']}}
{{$productOrderCtrl.translations['antibody.pdp.commerceCard.promotion.promocode']}}: {{promo.promoCode}} {{promo.promoTitle}} {{promo.promoDescription}}. {{$productOrderCtrl.translations['antibody.pdp.commerceCard.promotion.learnmore']}}
产品信息
67363-1-IG
种属反应
宿主/亚型
分类
类型
克隆号
抗原
偶联物
形式
浓度
纯化类型
保存液
内含物
保存条件
运输条件
产品详细信息
Aliquoting is unnecessary for -20°C storage.
靶标信息
The Na+/H+ antiporter (Nhe-1) is a ubiquitous membrane-bound enzyme involved in pH regulation of vertebrate cells and is specifically inhibited by the diuretic drug amiloride and activated by a variety of signals including growth factors, mitogens, neurotransmitters, and tumor promoters. Nhe-1 acts as an anchor for actin filaments to control the integrity of the cortical cytoskeleton. This occurs through a previously unrecognized structural link between Nhe-1 and the actin-binding proteins ezrin, radixin, and moesin, collectively referred to as ERM proteins. A structural role for Nhe-1 has been proposed in regulating the cortical cytoskeleton that is independent of its function as an ion exchanger. It is also thought that Nhe-1 play a role in hypertension. At least two isoforms of Nhe-1 are known to exist.
仅用于科研。不用于诊断过程。未经明确授权不得转售。
生物信息学
蛋白别名: APNH; Na(+)/H(+) antiporter, amiloride-sensitive; Na(+)/H(+) exchanger 1; Na-Li countertransporter; NHE-1; protein phosphatase 1, regulatory subunit 143; Sodium/hydrogen exchanger 1; Solute carrier family 9 (sodium/hydrogen exchanger 1), antiporter, Na+/H+, (amiloride sensitive); solute carrier family 9 (sodium/hydrogen exchanger), isoform 1 (antiporter, Na+/H+, amiloride sensitive); solute carrier family 9 (sodium/hydrogen exchanger), member 1; solute carrier family 9 (sodium/hydrogen exchanger), member 1 (antiporter, Na+/H+, amiloride sensitive); Solute carrier family 9 member 1; solute carrier family 9, member 1; solute carrier family 9, subfamily A (NHE1, cation proton antiporter 1), member 1
基因别名: APNH; APNH1; LIKNS; NHE-1; NHE1; PPP1R143; SLC9A1
UniProt ID: (Human) P19634, (Rat) P26431
Entrez Gene ID: (Human) 6548, (Rat) 24782